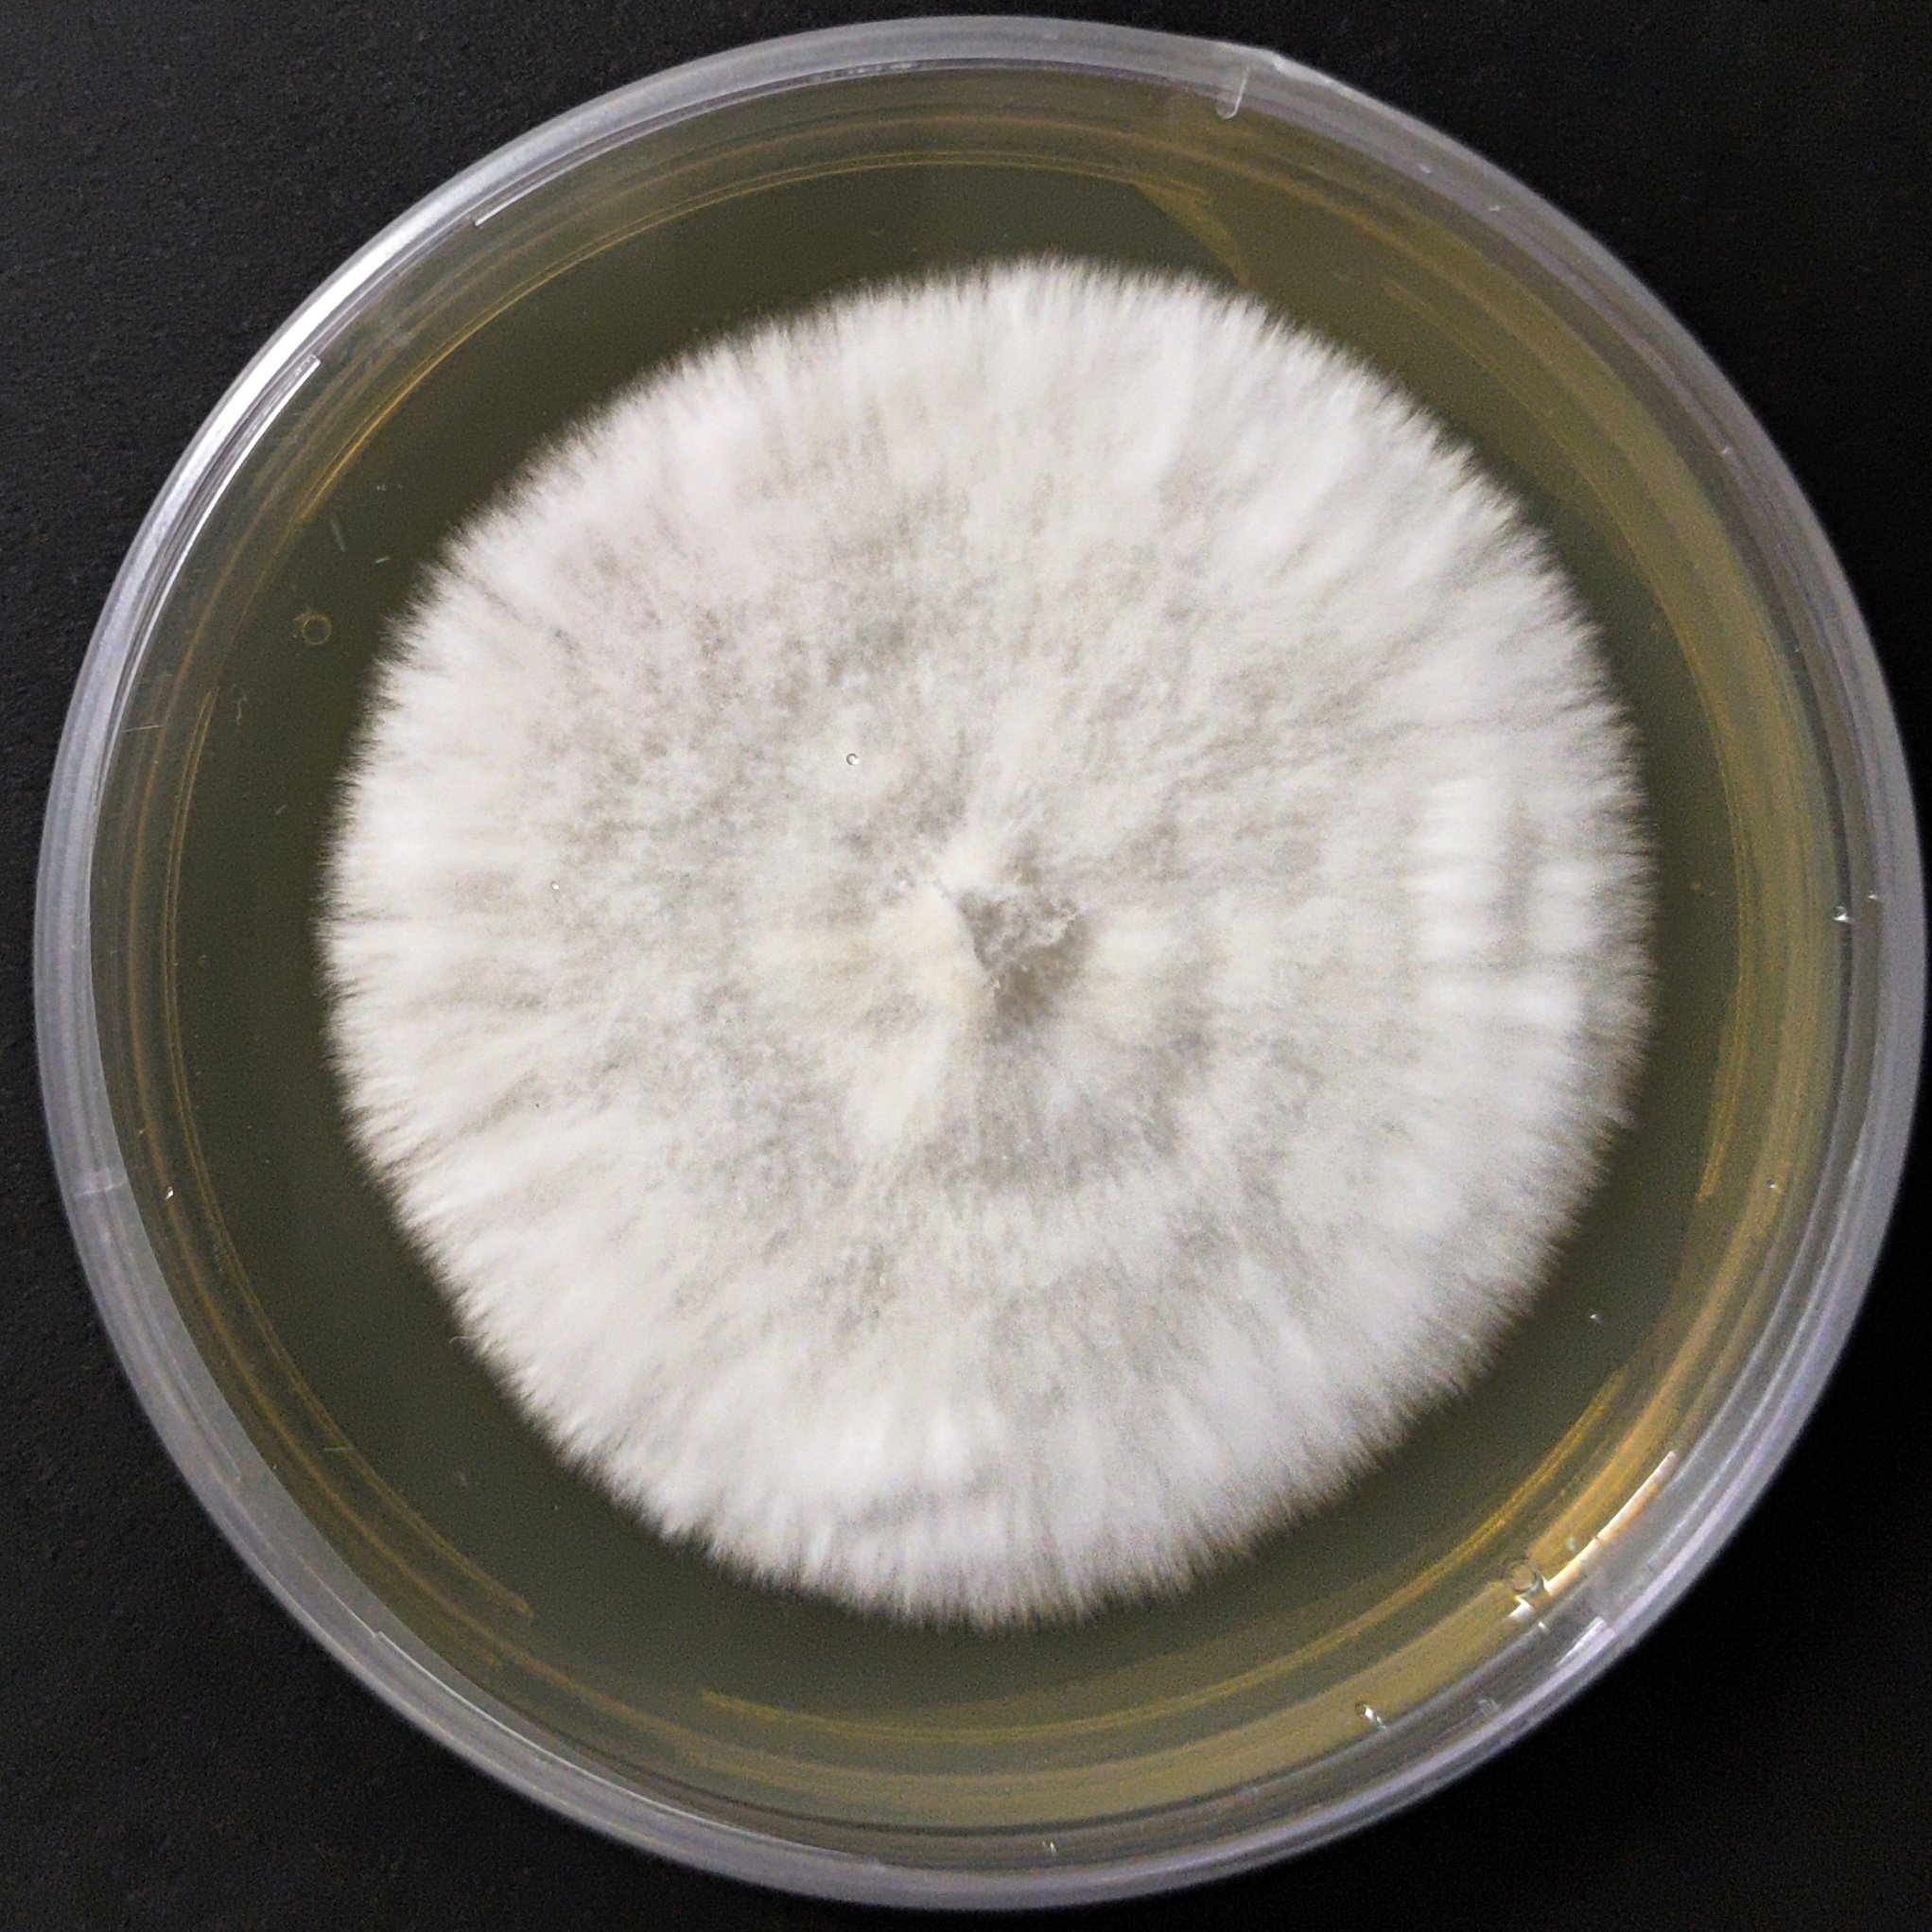
Indian Oyster Mushroom Culture Plate (Pleurotus pulmonarius)
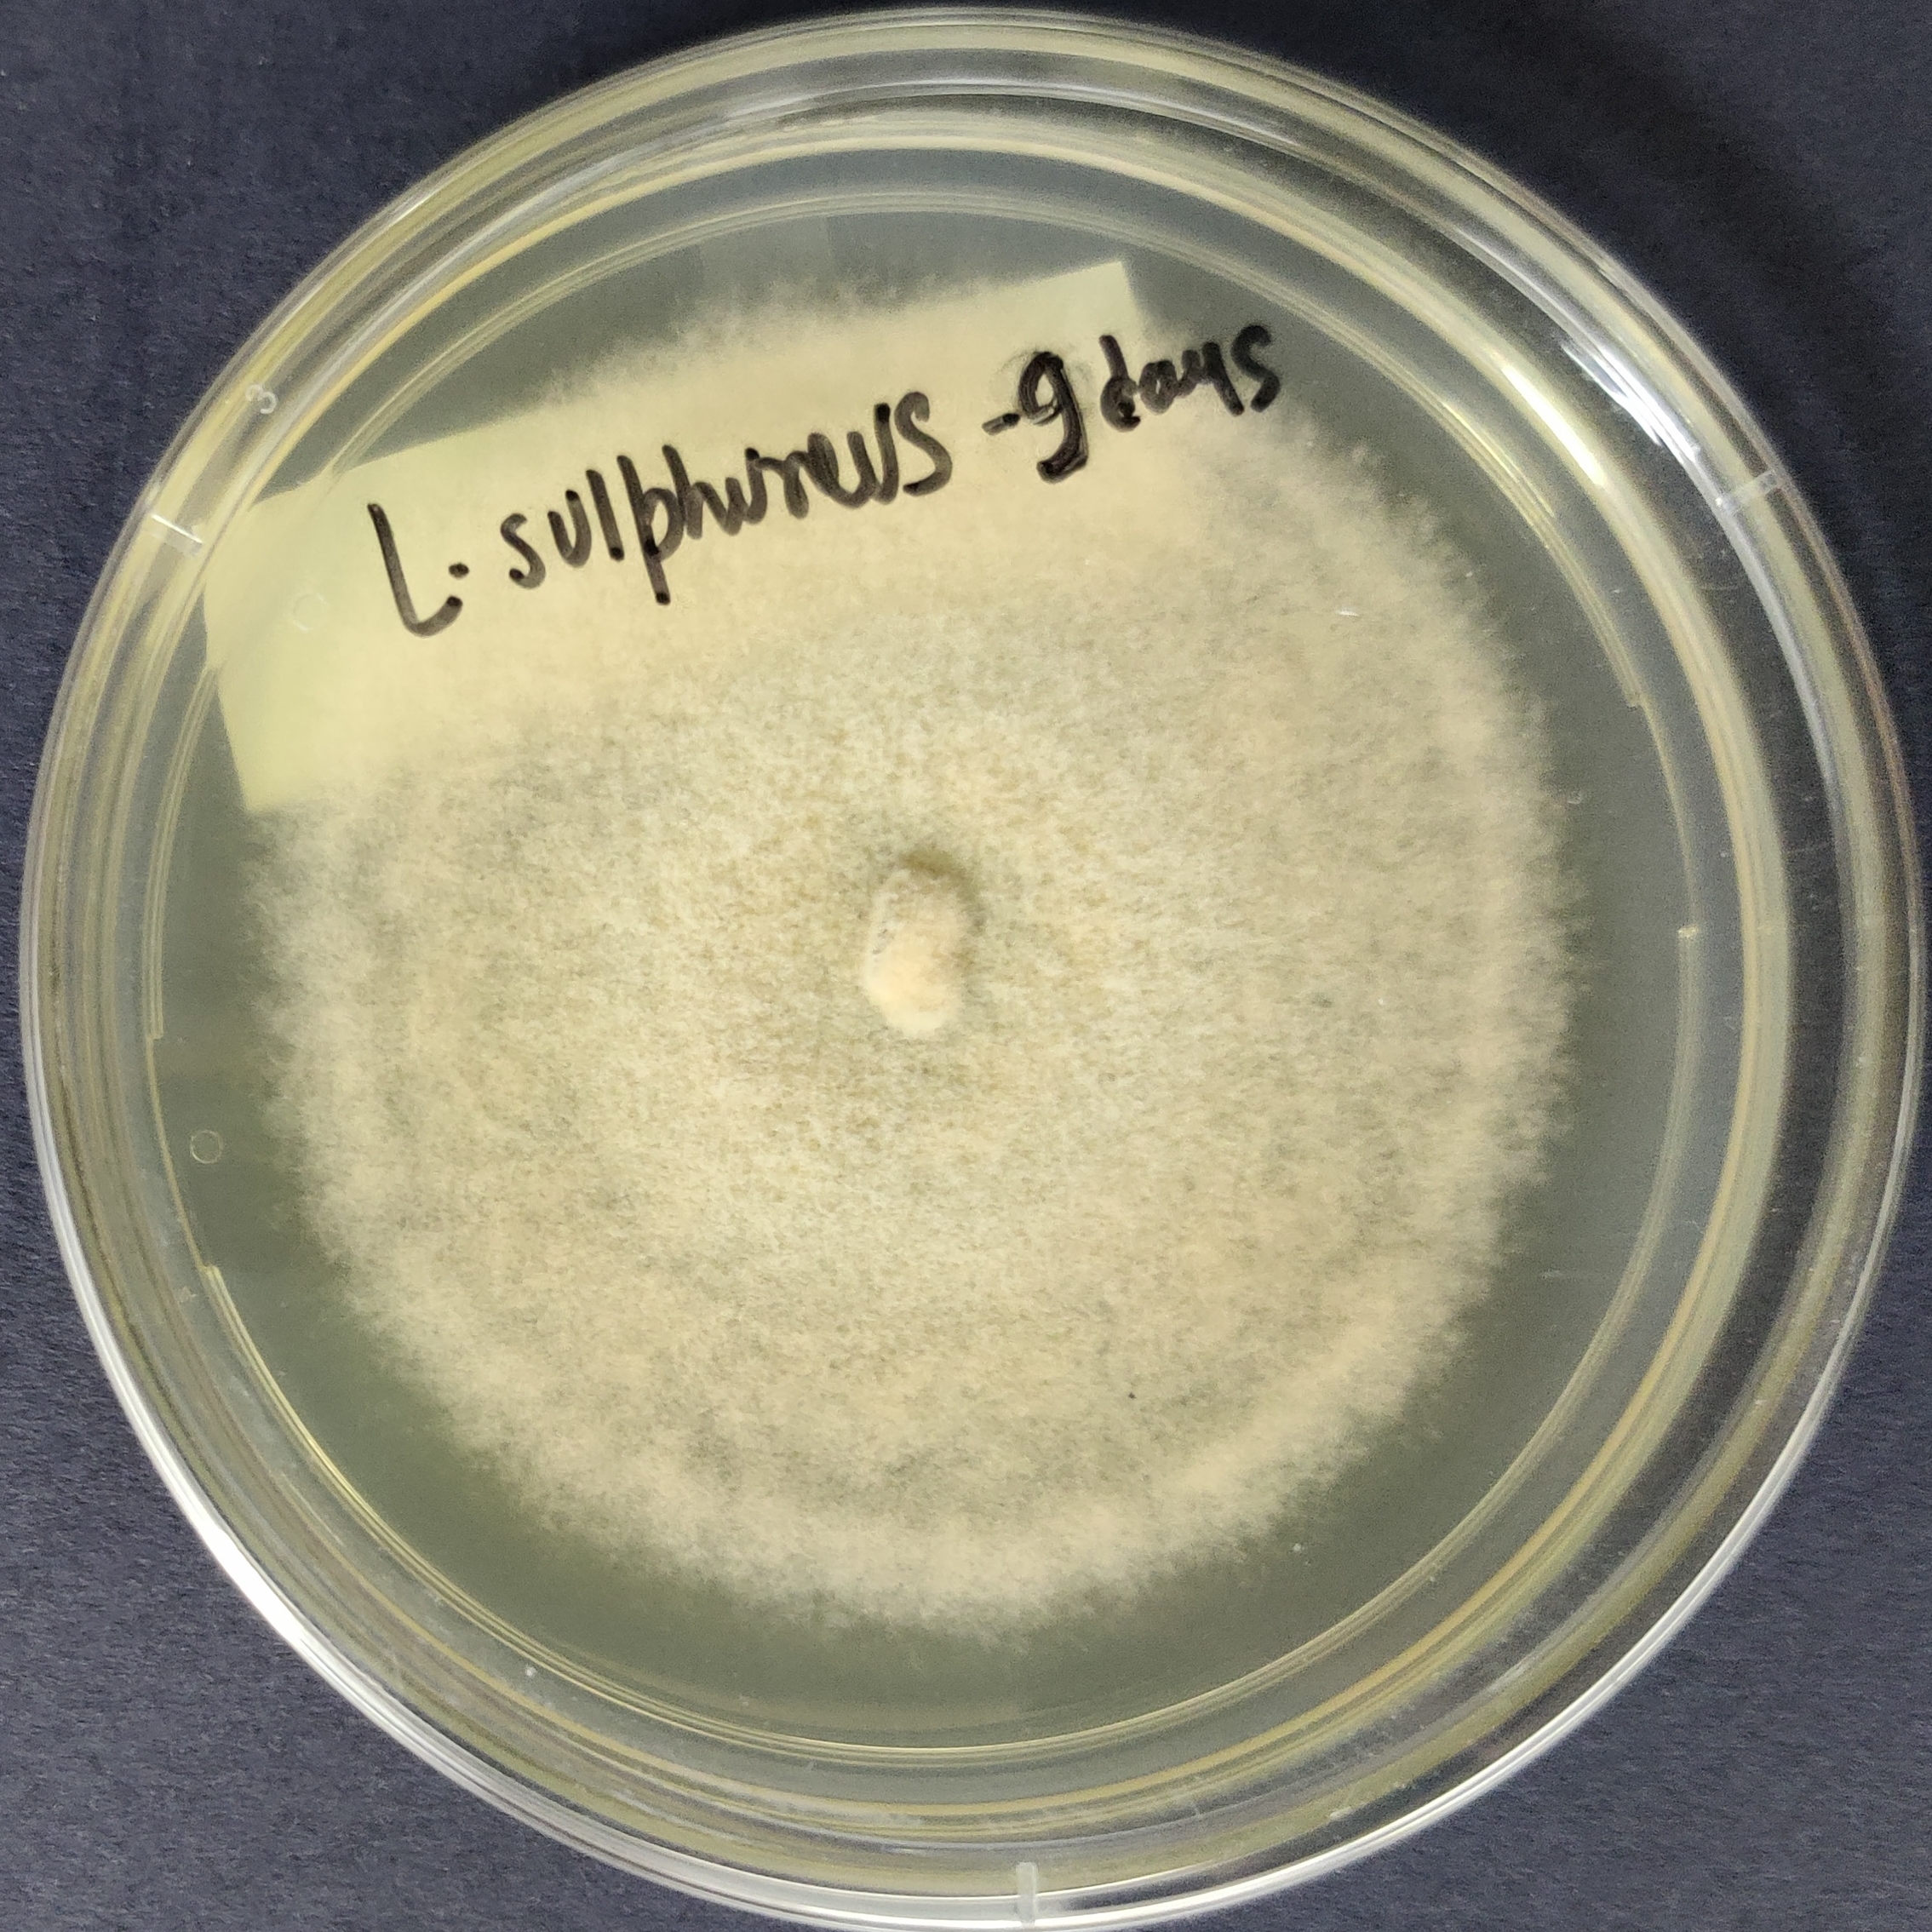
Laetiporus sulphureus Pure Culture (Chicken of the Woods)
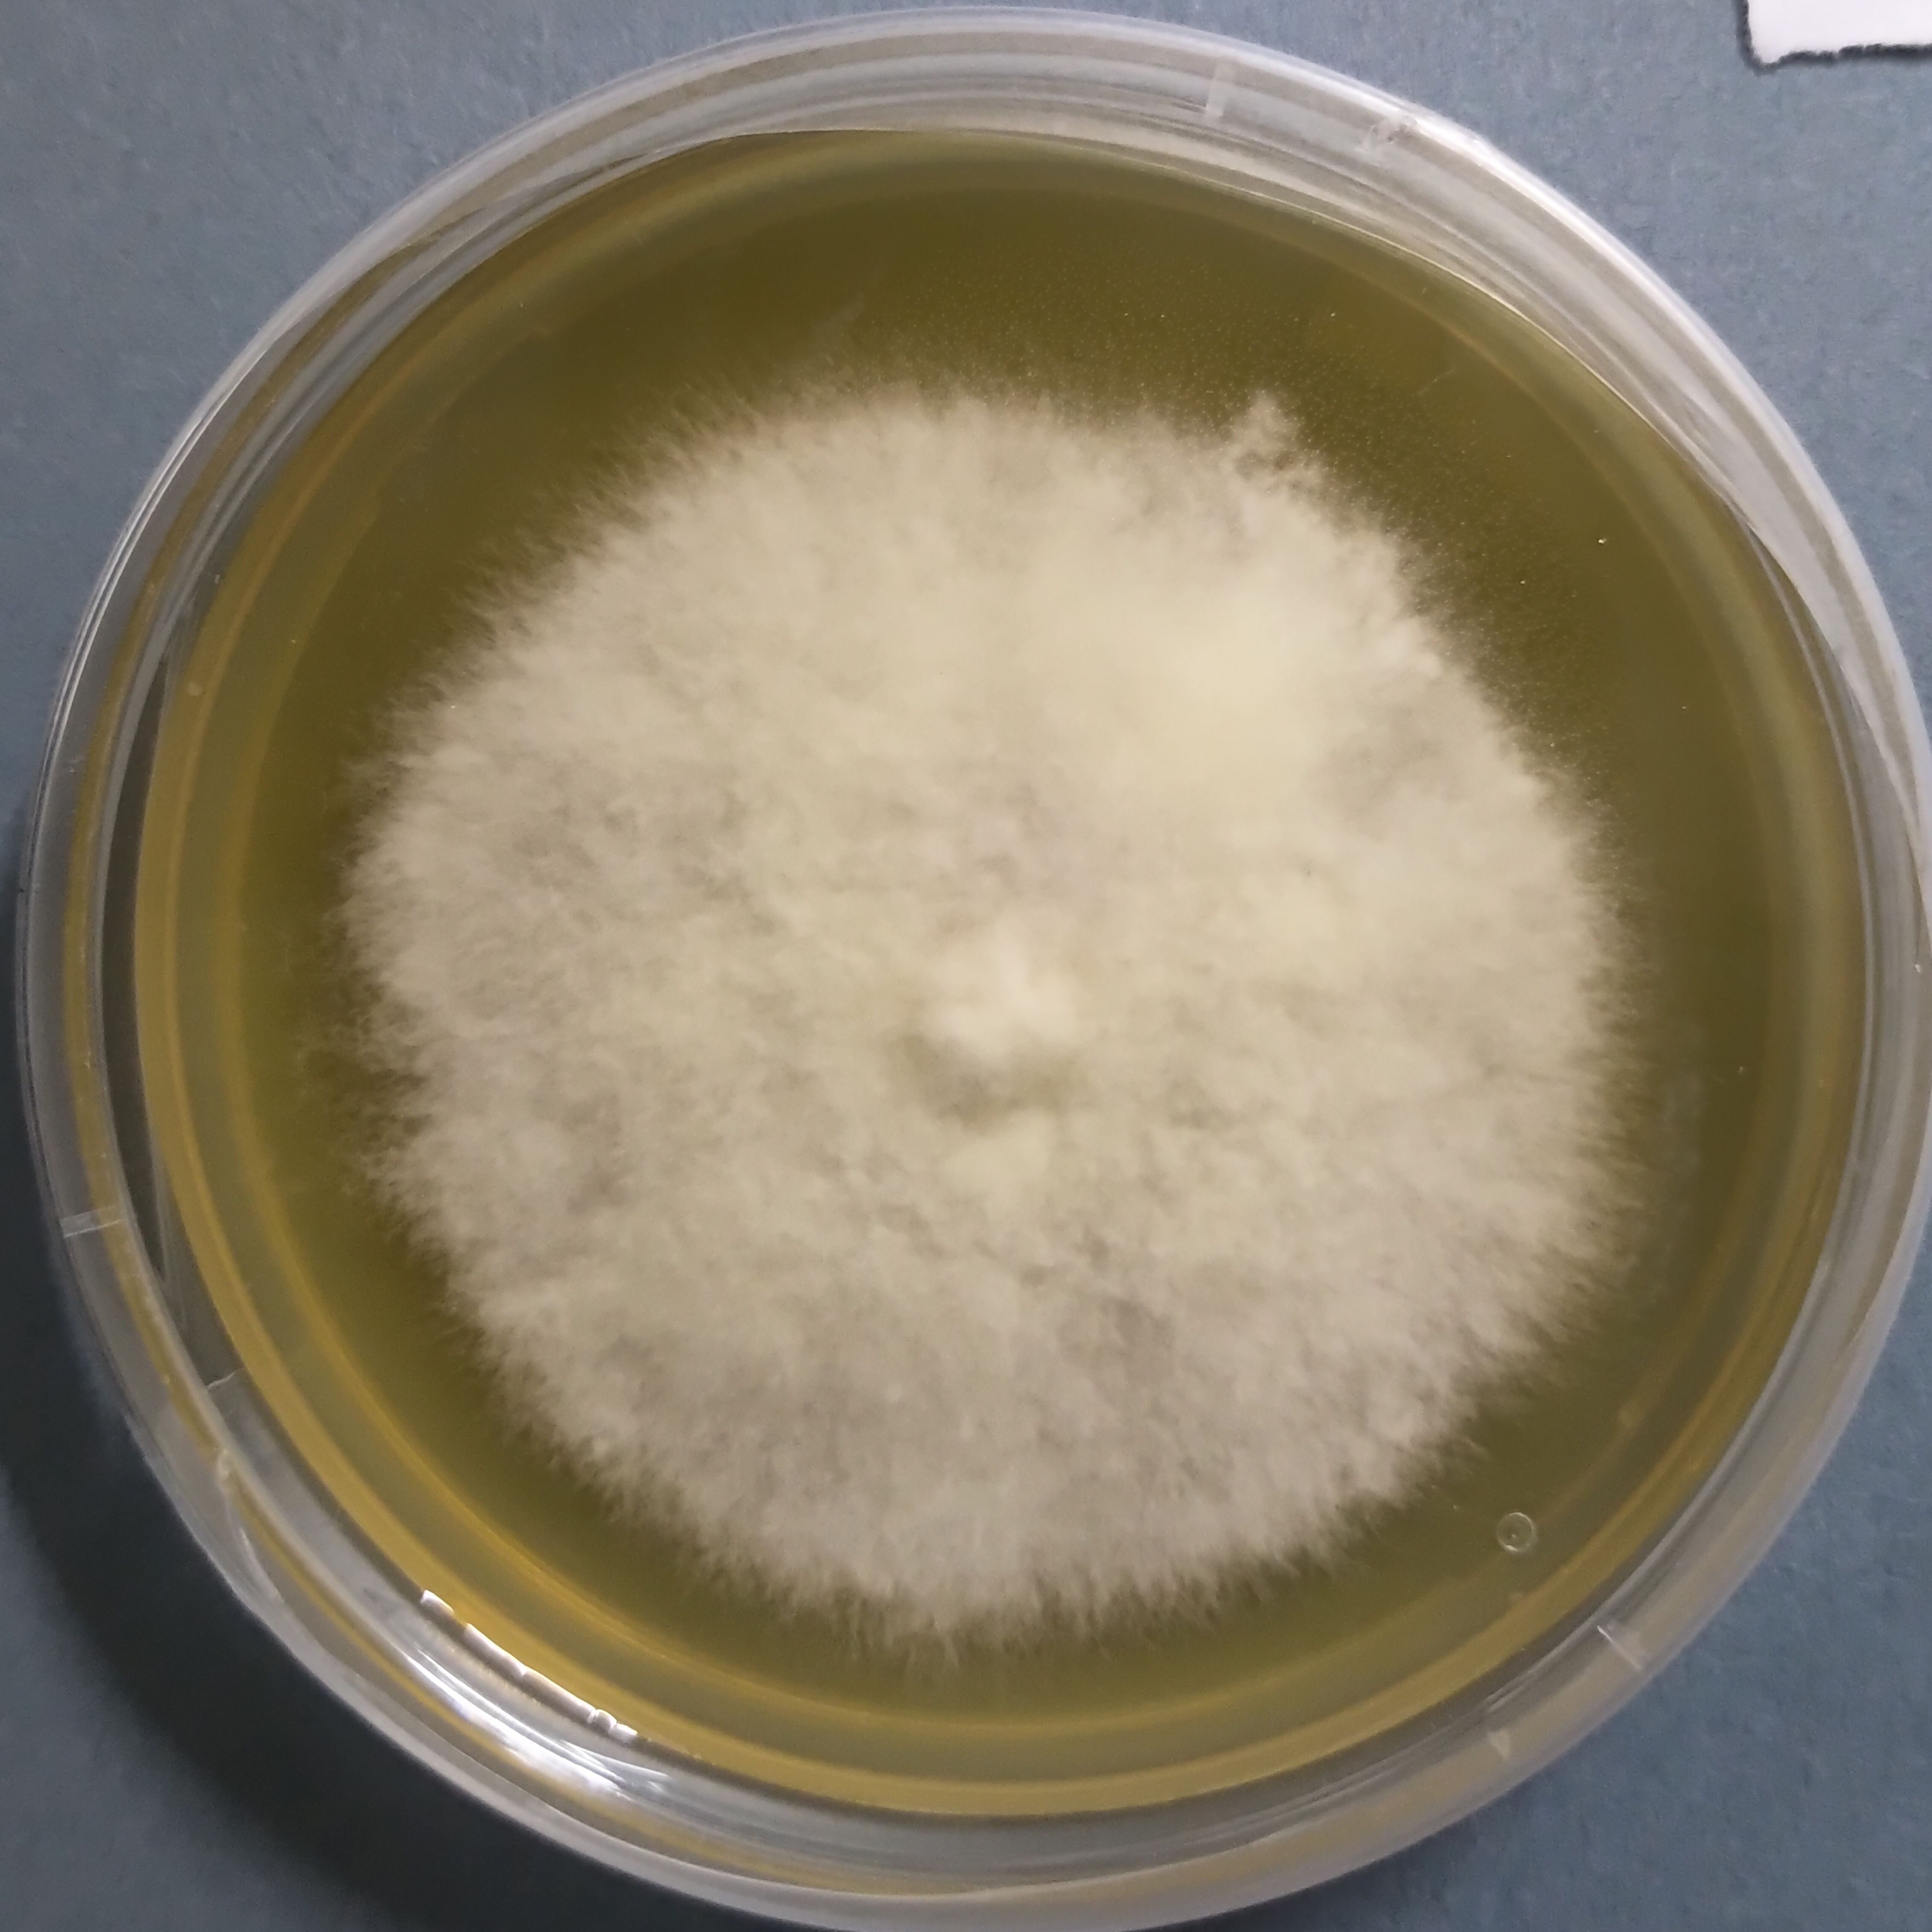
Maitake mushroom culture (Grifola frondosa)
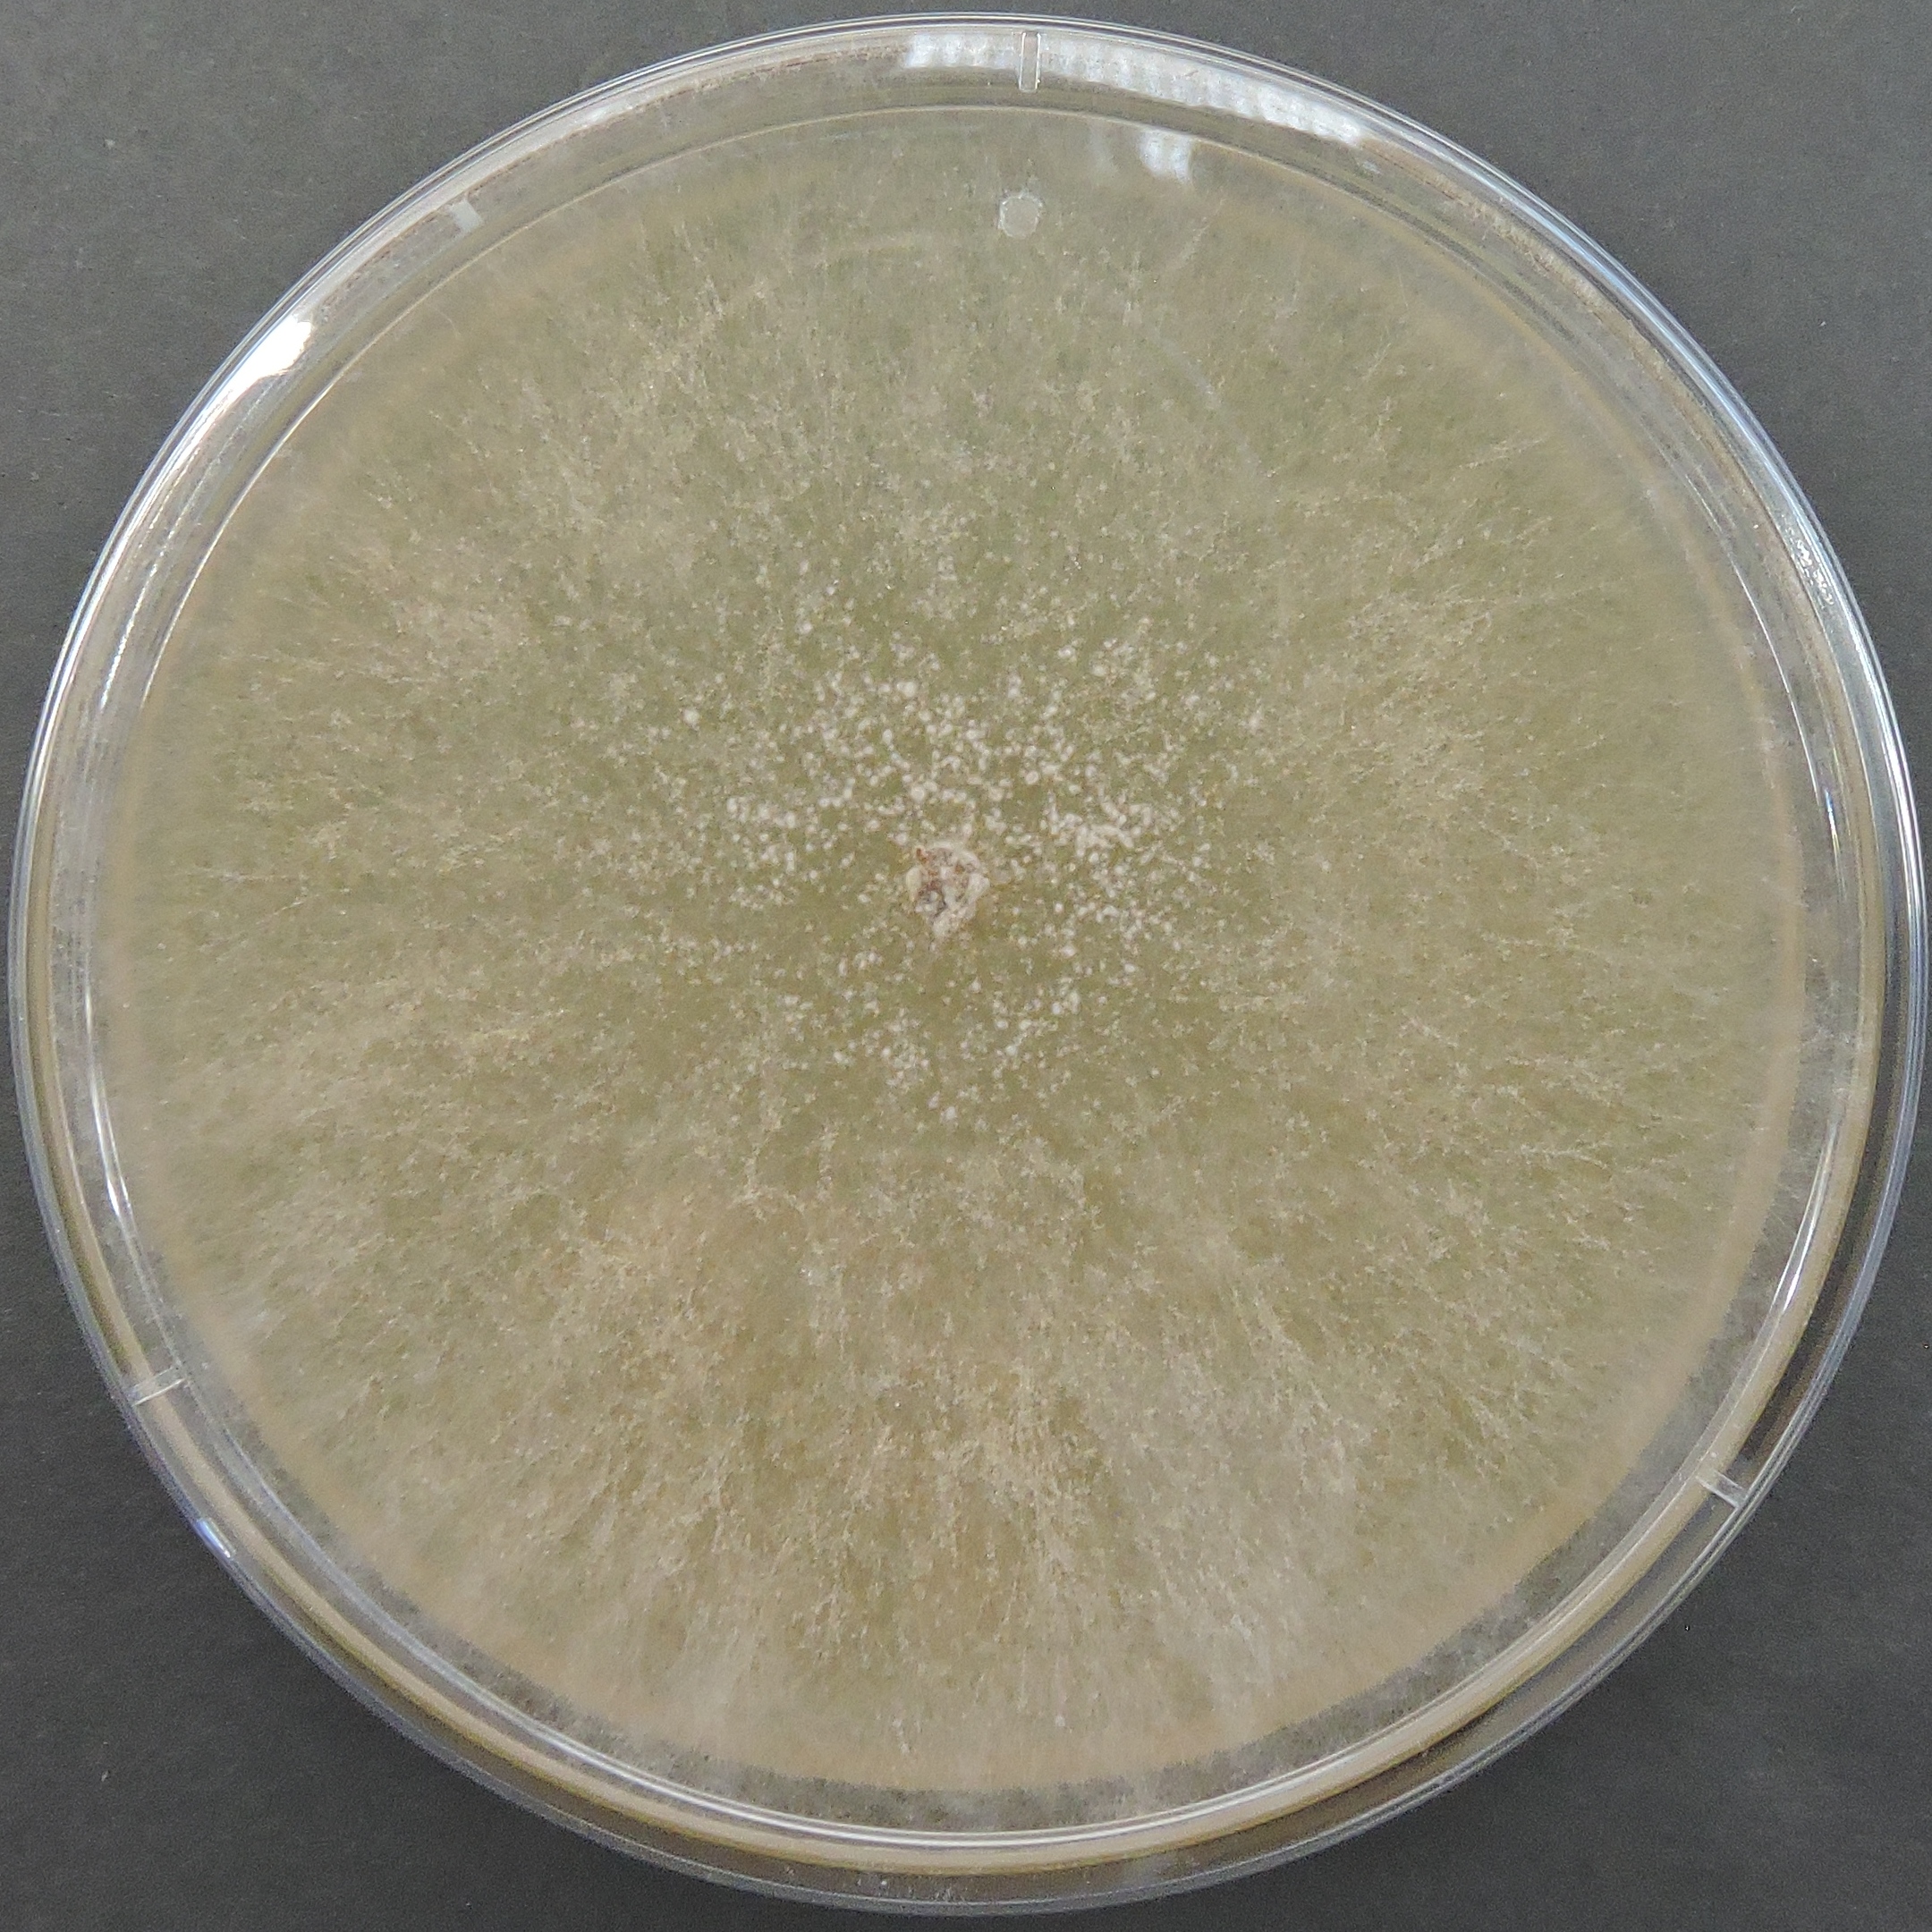
Paddy Straw Mushroom (Volvariella volvacea) Culture
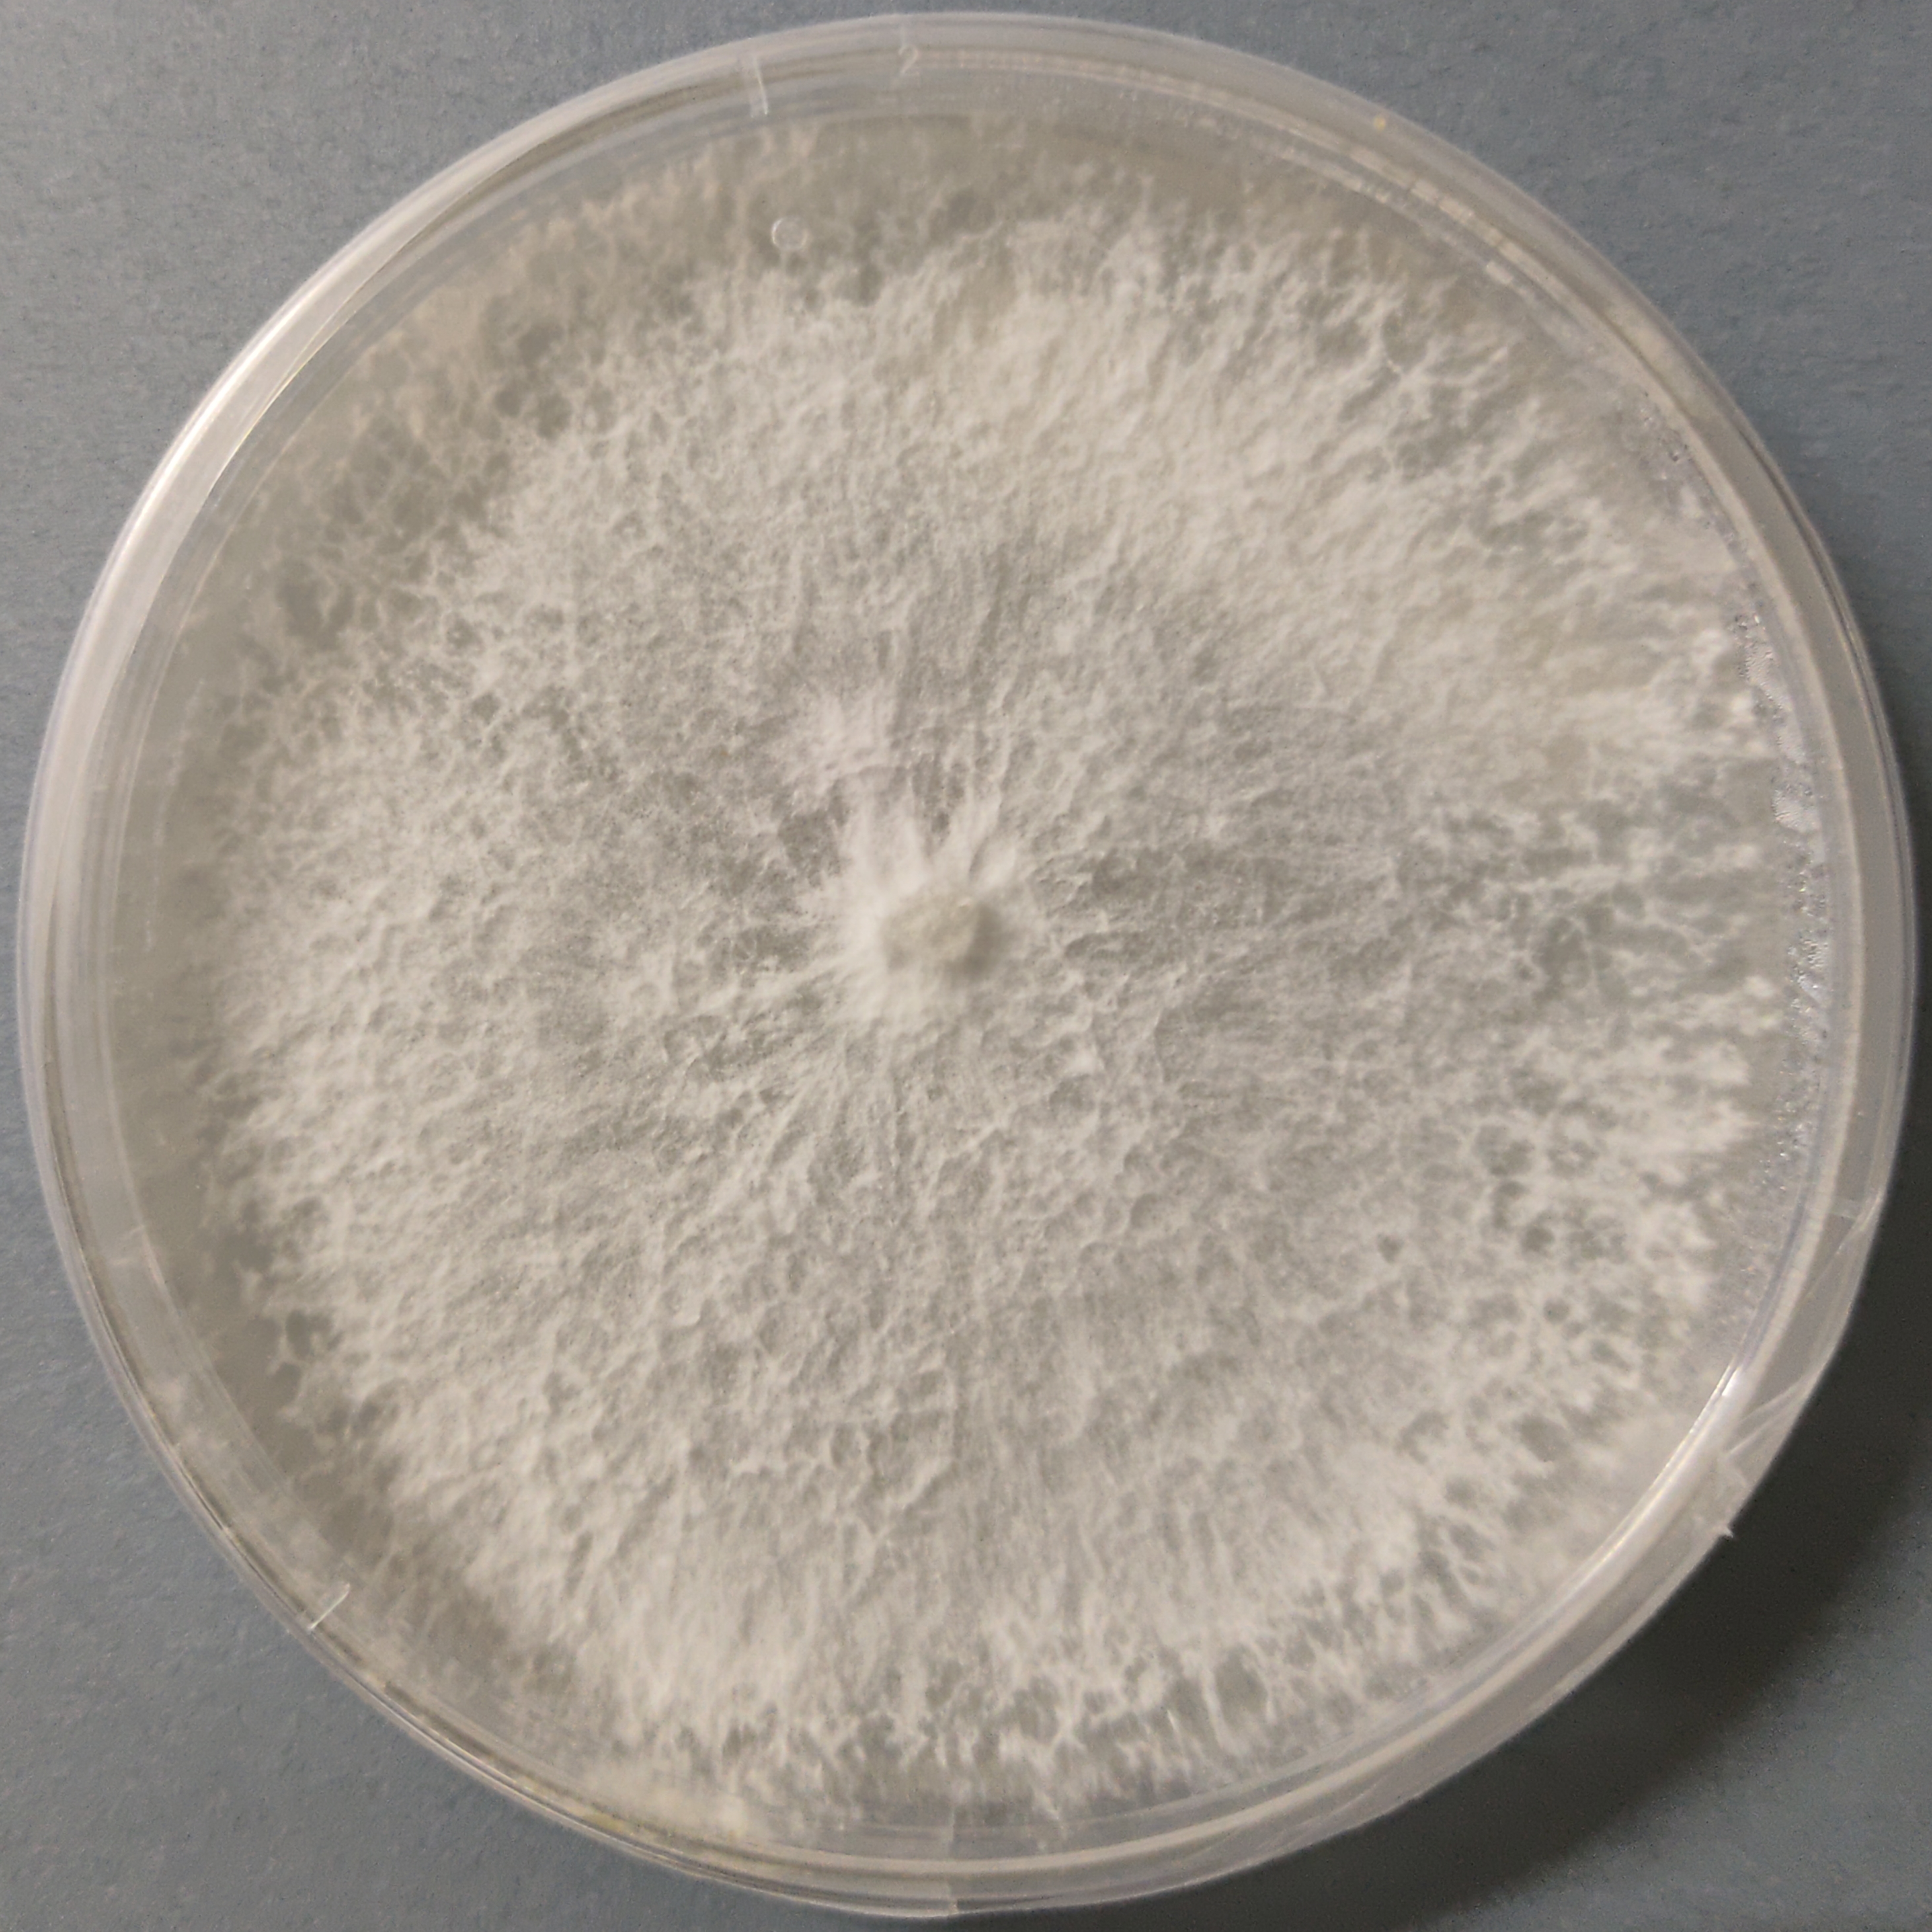
Princess Pearl Oyster mushroom Culture (Pleurotus ostreatus)
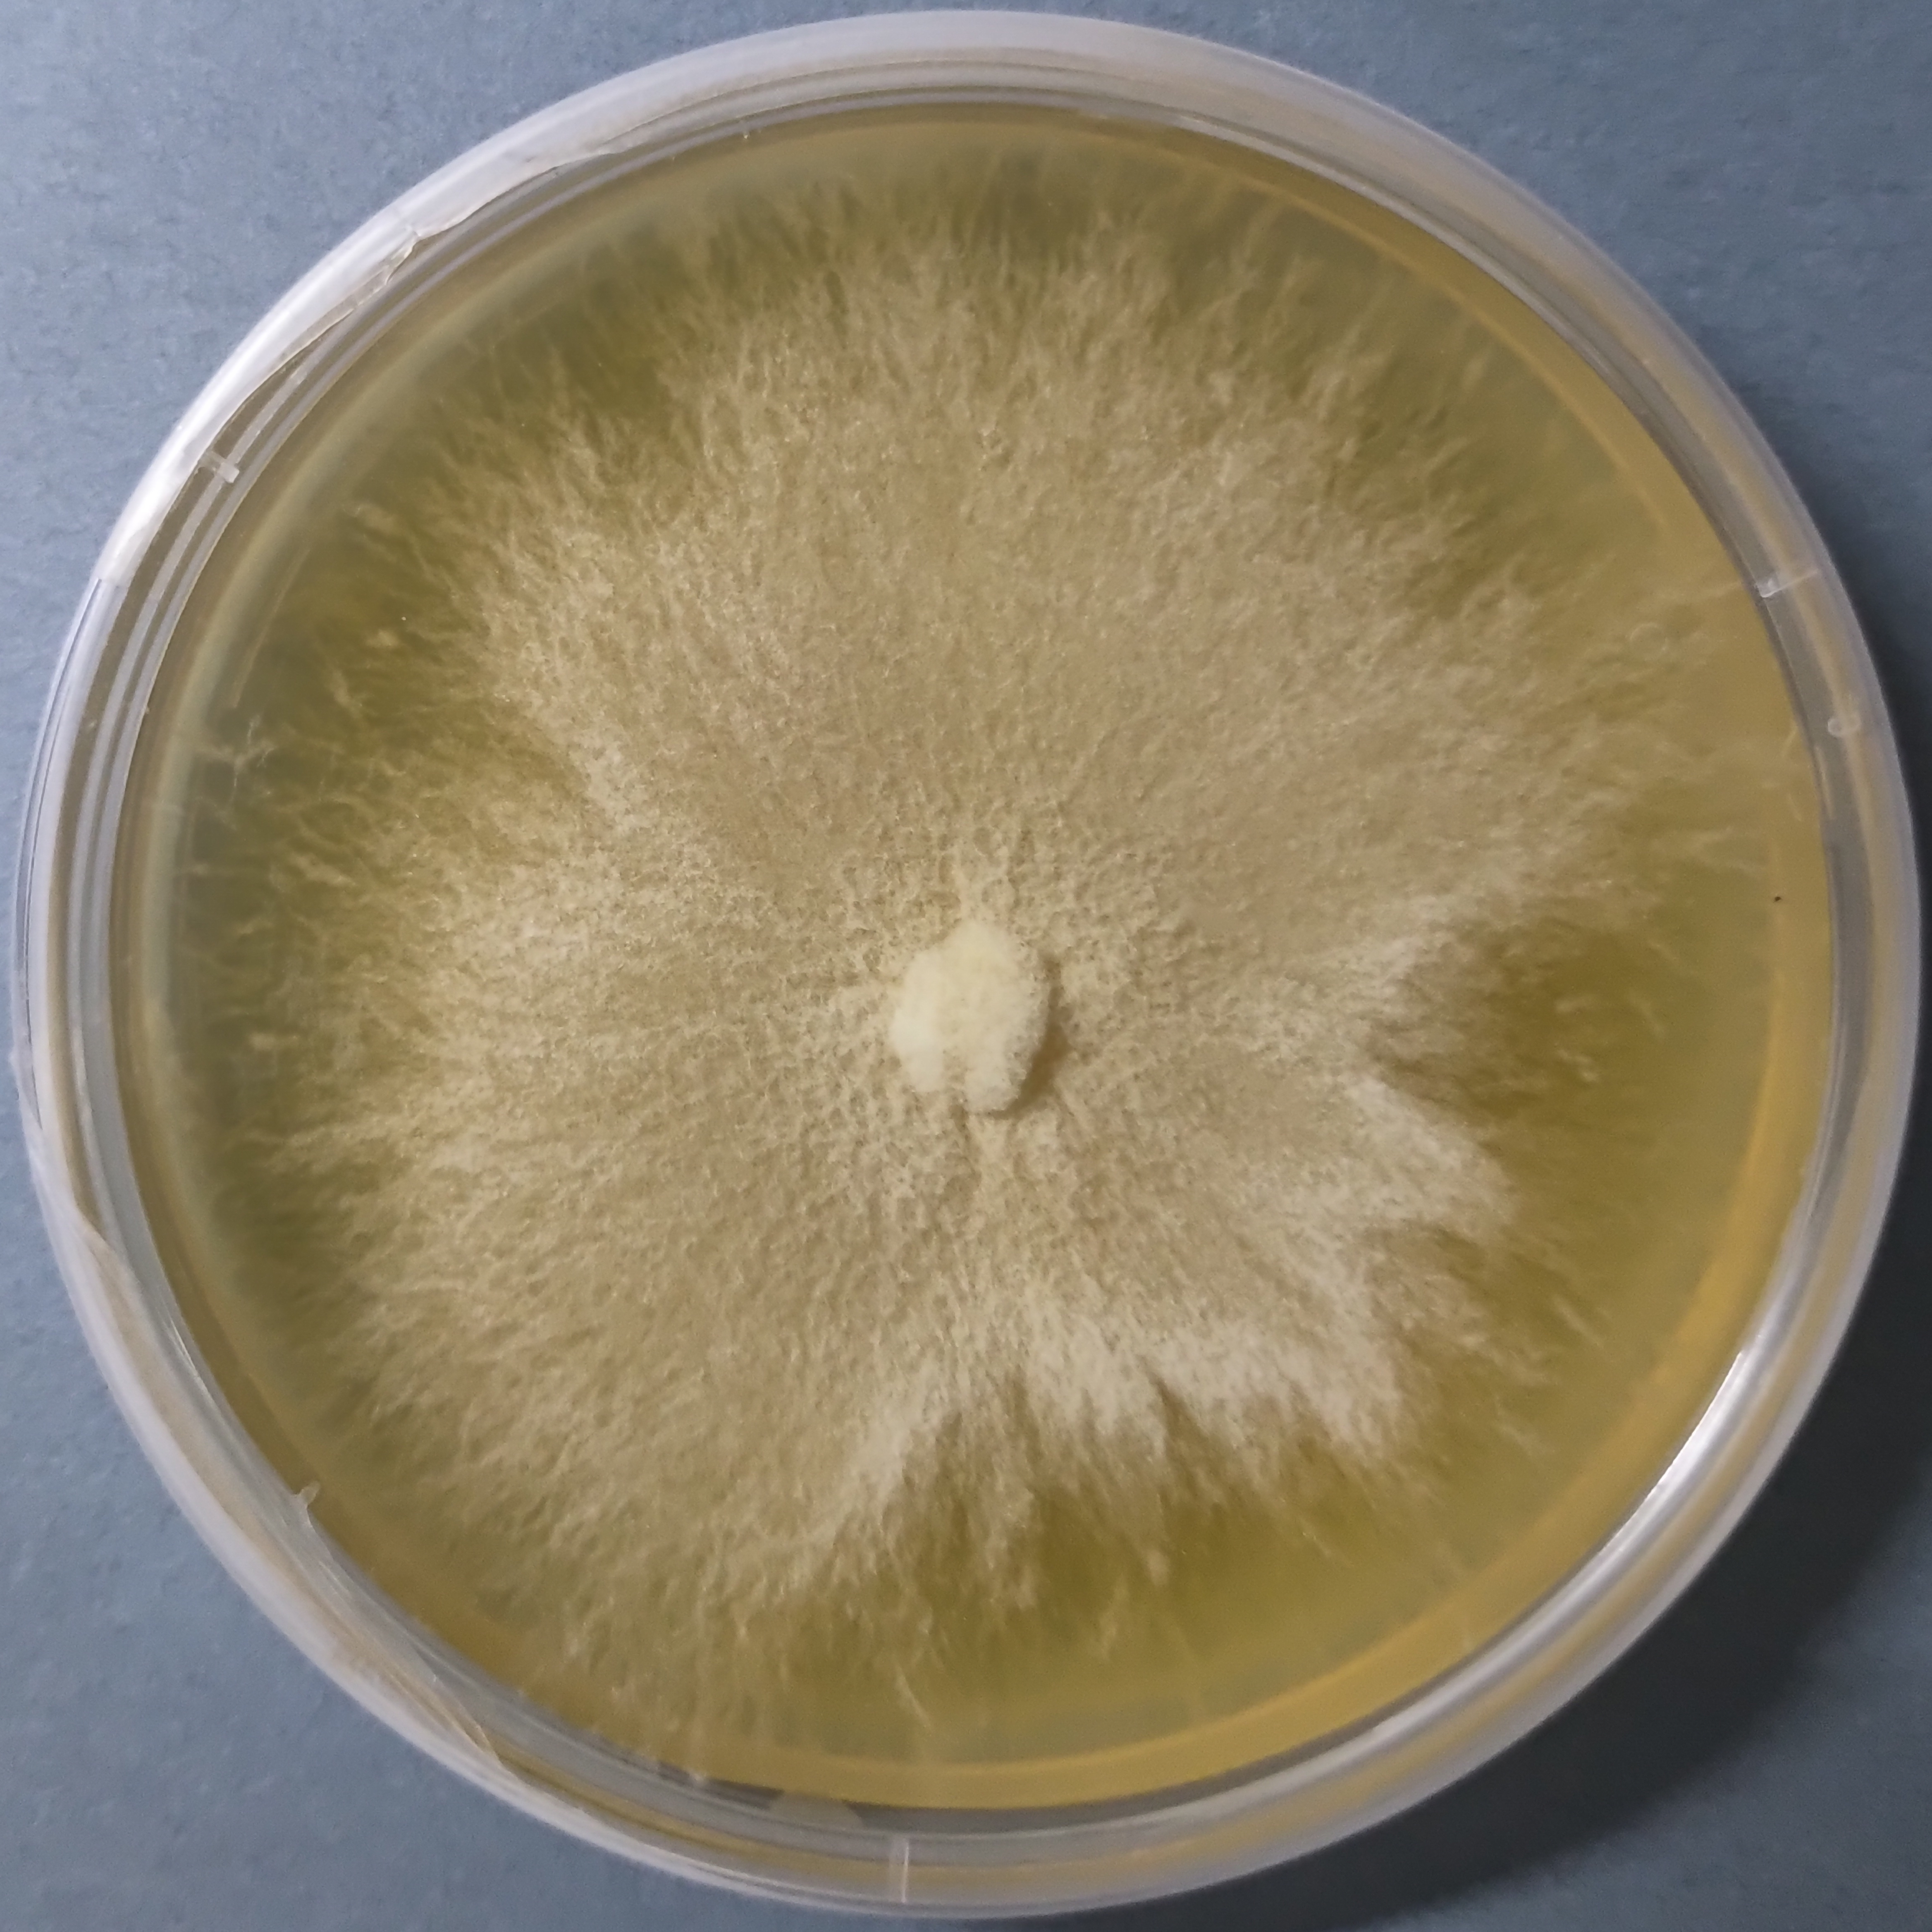
Sakura Oyster Mushroom Culture (Pleurotus djamor)

Liquid Culture Oyster Mushrooms
₹1,500.00
You’re now subscribed to price tracking for this product. We’ll notify you if the price drops.
The Liquid Culture Syringe – Oyster Mushrooms is a laboratory-prepared, contamination-free inoculum containing fast-growing oyster mushroom mycelium suspended in a sterile nutrient solution. This multi-variety offering includes 10 high-performing oyster mushroom strains, making it ideal for cultivators, trainers, research labs, and spawn producers who want diversity, speed, and reliability from a single product.
Oyster mushrooms (genus Pleurotus) are among the most versatile and commercially successful mushrooms worldwide, known for rapid colonization, high biological efficiency, and adaptability across substrates. Our liquid cultures are produced under controlled aseptic conditions to ensure high viability, vigorous mycelial growth, and uniform performance.
Choose one or more of these Oyster Mushroom Varieties
- Pleurotus citrinopileatus (Golden Oyster)
- Pleurotus columbinus (Blue Oyster)
- Pleurotus djamor (Sakura pink oyster)
- Pleurotus djamor var roseus (Pink oyster)
- Pleurotus eryngii (King oyster)
- Pleurotus eunosmus (Tarragon oyster)
- Pleurotus florida (white oyster)
- Pleurotus ostreatus (Princess Pearl)
- Pleurotus ostreatus (King of Pearl)
- Pleurotus ostreatus (Black pearl)
- Pleurotus ostreatus (Blue pearl)
- Pleurotus ostreatus (King blue)
- Pleurotus pulmonaris (India oyster)
- Pleurotus ferule (White ferule)
- Pleurotus salmoneostramineus (Pink Oyster)
(Exact strain selection may vary based on availability and performance.)
Key Features
-
Format: Sterile liquid culture syringe
-
Volume: Typically 10 ml (as specified)
-
High mycelial density for rapid colonization
-
Suitable for grain spawn, agar work, and liquid-to-liquid transfer
-
Ideal for beginners, commercial growers, and training programs
Applications
-
Commercial oyster mushroom cultivation
-
Spawn production and scale-up
-
Mycology research and strain comparison
-
Training, demonstrations, and incubation trials
Storage & Handling
-
Can be stored at 4–8 °C (refrigerated) for 3 months
-
Use within recommended viability period
-
Maintain sterile handling during inoculation
Only logged in customers who have purchased this product may leave a review.

Reviews
There are no reviews yet.